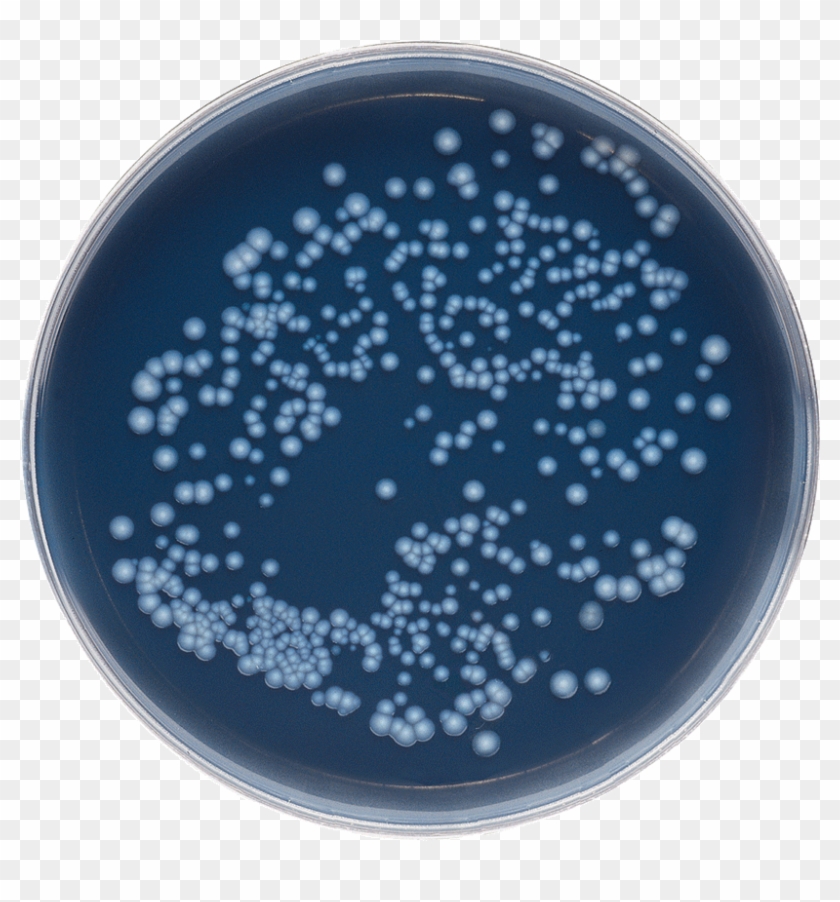
Solutions For Legionella - Gvpc Legionella Clipart #5267002

You're welcome to embed this image in your website/blog!
Text link to this page:
Medium size image for your website/blog:
PNG Properties
- Share PikPng
- License Personal Use
-
- Resolution 900x900
- Name Solutions For Legionella - Gvpc Legionella Clipart
- Size 525 KB
-
Ralate Tags